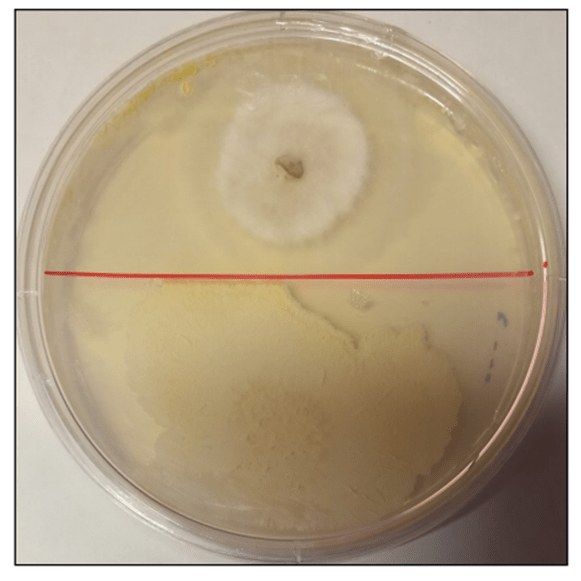

Durante el 2022-2023 se realizaron una serie de mejoras a los productos biológicos sanitarios de Quimcasa. Estas mejoras se obtuvieron mediante la identificación y selección de cepas bacterianas presentes en cada uno de los productos; dichas cepas tienen las siguientes características:
Mayor producción de biopelículas (biofilms)
La formación de biopelículas es un proceso en el cual las células de microorganismos se agregan para formar colectivos que se encuentran embebidos en una matriz extracelular producidas por dichas células, que además les facilita la fijación a superficies, por ejemplo, al sistema radicular de la planta, a sus hojas (generando una mejor colonización de la planta), o a las hifas de los hongos.
Además de las ventajas mencionadas de tener colonias bacterianas que producen una mayor cantidad de biopelícula (creación de una colonia, fijación al sistema radicular, hojas, o a las hifas de hongos), también las biopelículas pueden generar sinergia cuando se producen biopelículas producidas por diferentes organismos benéficos, por ejemplo Bacillus subtilis cuando cohabita con Pantoea agglomerans tienen una mayor resistencia a antibióticos que pudieran ser producidos por hongos fitopatógenos.
Incremento en la producción de compuestos antimicrobianos. Mejora en la antibiosis
Las bacterias pertenecientes a Bacillus subtilis ueden una gran variedad de antibióticos con capacidad de inhibir el crecimiento de agentes fitopatógenos, mediante la selección realizada, se eligieron las cepas que produjeron la mayor antibiosis ante diferentes organismos fitopatógenos.

Gracias a esta selección se logró obtener un insumo de control biológico con alta capacidad de coloni- zación y con una alta capacidad de generar antibiosis contra diferentes organismos fitopatógenos, que se ven expresados en un mejor control biológico de enfermedades en cultivos en campo abierto y de agricultura protegida.
